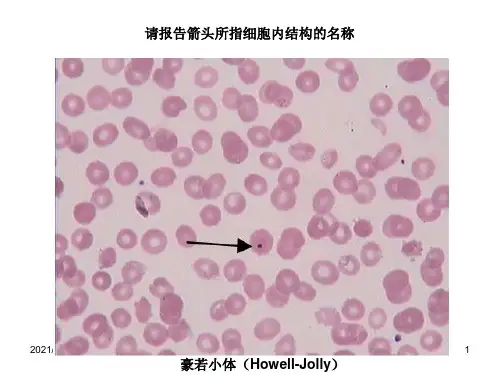
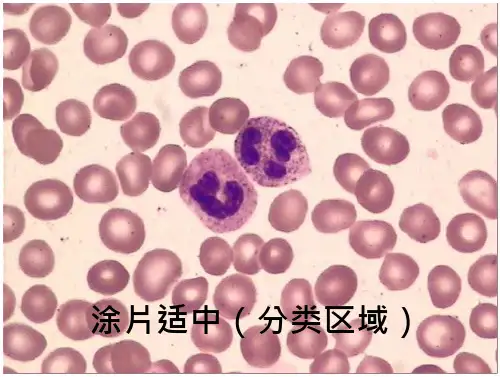

血细胞图谱大全
- 格式:ppt
- 大小:15.04 MB
- 文档页数:23

血液一般检验连云港市第一人民医院检验科临检室图2-1-扫描电镜正常红细胞图2-10-缗钱状图2-11-嗜多色图2-12-嗜碱点彩红图2-13-染色质小体图2-14-卡波环图2-15-有核红细胞图2-16-血细胞比容结果判断图2-17-网织红细胞图2-18-Miller窥盘结构示意图图2-19-网织红细胞计数鉴别正图2-2-正常红细胞图2-20-网织红细胞计数鉴别小图2-21-网织红细胞计数鉴别大图2-22-中性粒细胞分化发育动图2-23-中性粒细胞类白血病图2-24-嗜酸粒细胞类白血病图2-25-正常五种白细胞图2-26-中性杆状核图2-27-中性粒细胞分叶核图2-28-中性粒细胞大小不均图2-29-中毒颗粒图2-3-红细胞大小不均图2-30-空泡形成图2-31-杜勒小体图2-32-中性粒细胞退行性变图2-33-棒状小体图2-34-中性粒细胞的核象变化图2-35-中性粒细胞核左移图2-36-中性粒细胞核右移图2-37-巨多核中性粒细胞图2-38-巨杆状核1图2-39-过分叶核中性粒细胞图2-4-巨红图2-40-双核中性粒细胞图2-41-环形核中性粒细胞和核图2-42-Chediak-higashi畸形图2-43-Alder-Reilly畸形图2-44-May-Hegglin畸形图2-45-Pelger-Huet畸形图2-46-异型淋巴1图2-47-异型淋巴Ⅱ图2-48-异型淋巴Ⅲ图2-49-卫星核淋巴细胞图2-5-球形红图2-50-正常血小板图2-51-大血小板图2-52-异常形态血小板图2-53-血小板卫星现象图2-54-血小板聚集图2-55-正常止血机制图2-56-PT检测原理图2-57-APTT检测原理图2-6-椭圆红细胞图2-7-靶红图2-8-棘形红图2-9-泪滴形红细胞。

各种血细胞模式图1.红细胞2.嗜酸性粒细胞3.嗜碱性粒细胞4.中性粒细胞5.淋巴细胞6.单核细胞7.血小板红细胞聚集分布成熟红细胞随机呈块状或束状聚集在一起,临床主要表现为以下病症:1.多种抗体暴露;2.溶血性贫血(自身免疫性);3.非典型肺炎;4.金葡菌感染;5.冷凝集疾病。
靶形红细胞红细胞中央色深,外周以苍白圈,在近红细胞边缘处又较深。
形同射击之靶,在正常情况下靶形细胞极少见。
但性贫血,尤其是在地中海贫血的血涂片上颇为常见。
镰状红细胞这种红细胞两端尖锐,长而狭,形如镰刀样,见于先天性镰状红细胞贫血和Hb-C病等Bite Cell 红细胞由于细胞内血红蛋白变性或沉淀成块,使细胞呈半圆形,提示可能有红细胞膜的缺乏,如G-6-PD缺乏症。
水滴形红细胞红细胞形态如梨形或水滴形,见于各种增生性贫血及骨髓纤维化,以及地中海贫血、脾功能亢进或肾病等。
固缩红细胞红细胞中有一侧清晰区,而血红蛋白浓缩偏向另一侧,临床上常见于婴儿固缩红细胞增多症。
半月形红细胞胞体巨大,呈月形,淡红色。
为衰老红细胞在制片时人工造成,或见于某些增生性贫血、血小管球性肾炎。
刺毛红细胞亦称锯凿细胞。
包括刺细胞、钻细胞及距细胞。
往往见于微血管病性溶血性贫血、丙酮酸激酶缺乏症、PNH,距见于尿毒症。
球形红细胞此种红细胞直径缩短,厚度增加,细胞中心区的血红蛋白比周围多,呈小球形状。
常见于遗传形红细胞增多症、红蛋白病(如Hb-S等)。
椭圆形红细胞红细胞呈椭圆形,横径缩短,长径增大,正常人椭圆形红细胞也可高达15%。
这种红细胞多见于遗传性椭圆形红25%,一般要高于25%-50%才有诊断价值。
在大红细胞性贫血可达25%,恶性贫血及严重缺铁性贫血、地中海贫血口形红细胞口形红细胞的中心淡染区呈条状,这种细胞正常小于4%,增高见于口细胞增多症,急性酒精性中毒时可大于5%裂红细胞指红细胞碎片,包括盔形红细胞等,多见于弥散性血管内凝血、微血管病性溶血性贫血和心源性溶血性贫血等红学中毒、肾功能衰竭、血栓性血小板减少性紫癜。

血细胞形态图库1
彩图1红系细胞形态a ,成熟红细胞; b ,原红细胞; c ,早幼红细胞; d ,中幼红细胞;
e ,中幼红细胞;
f ,晚幼红细胞
彩图2 粒系细胞形态 a 、b ,原粒细胞;c ,早幼粒细胞;d ,中性中幼粒细胞;e ,中性晚幼粒细胞;f ,中性杆状核粒细胞(红箭头),中性分叶核粒细胞(黑箭头);g ,嗜酸性粒细胞;h ,嗜碱性粒细胞
a b c
d e
f
a b c d
e f g h
彩图3 各阶段单核细胞形态图 100× a ,原单细胞;b ,幼单细胞;c 、d ,单
核细胞
彩图4 各阶段淋巴细胞形态图 100× a ,原淋细胞;b ,幼淋细胞;c ,淋巴细
胞;d ,大淋巴细胞
a b
c
d
a b
c d
彩图5 各阶段浆细胞形态图 100× a ,原浆细胞;b ,幼浆细胞;c ,浆细胞
彩图6 各阶段巨核细胞形态图 100× a ,原巨核细胞;b ,幼巨核细胞;c ,颗粒巨核细胞; d 、e ,产板巨核细胞;f ,裸巨核细胞
a b
c
a b c
d e f
彩图7 几种非造血细胞形态图 100× a ,破骨细胞;b ,组织嗜碱细胞(红箭头),网状细胞(黑箭头);c ,脂肪细胞
a b c。


各种血细胞模式图1、红细胞2、嗜酸性粒细胞3、嗜碱性粒细胞4、中性粒细胞5、淋巴细胞6、单核细胞7、血小板红细胞聚集分布成熟红细胞随机呈块状或束状聚集在一起,临床主要表现为以下病症:1、多种抗体暴露;2、溶血性贫血(自身免疫性);3、非典型肺炎;4、金葡菌感染;5、冷凝集疾病。
靶形红细胞红细胞中央色深,外周以苍白圈,在近红细胞边缘处又较深。
形同射击之靶,在正常情况下靶形细胞极少见。
但在黄疸、肝病、脾切除后,缺铁性贫血,尤其就是在地中海贫血的血涂片上颇为常见。
镰状红细胞这种红细胞两端尖锐,长而狭,形如镰刀样,见于先天性镰状红细胞贫血与Hb-C病等Bite Cell 红细胞由于细胞内血红蛋白变性或沉淀成块,使细胞呈半圆形,提示可能有红细胞膜的缺乏,如G-6-PD缺乏症。
水滴形红细胞红细胞形态如梨形或水滴形,见于各种增生性贫血及骨髓纤维化,以及地中海贫血、脾功能亢进或肾病等。
固缩红细胞红细胞中有一侧清晰区,而血红蛋白浓缩偏向另一侧,临床上常见于婴儿固缩红细胞增多症。
半月形红细胞胞体巨大,呈月形,淡红色。
为衰老红细胞在制片时人工造成,或见于某些增生性贫血、血小管球性肾炎。
刺毛红细胞亦称锯凿细胞。
包括刺细胞、钻细胞及距细胞。
往往见于微血管病性溶血性贫血、丙酮酸激酶缺乏症、PNH,距细胞多见于肝脏疾病,钻细胞也见于尿毒症。
球形红细胞此种红细胞直径缩短,厚度增加,细胞中心区的血红蛋白比周围多,呈小球形状。
常见于遗传形红细胞增多症、自身免疫性溶血性贫血、异常血红蛋白病(如Hb-S等)。
椭圆形红细胞红细胞呈椭圆形,横径缩短,长径增大,正常人椭圆形红细胞也可高达15%。
这种红细胞多见于遗传性椭圆形红细胞增多症,这种红细胞至少占25%,一般要高于25%-50%才有诊断价值。
在大红细胞性贫血可达25%,恶性贫血及严重缺铁性贫血、地中海贫血及镰刀形贫血也可见此细胞。
口形红细胞口形红细胞的中心淡染区呈条状,这种细胞正常小于4%,增高见于口细胞增多症,急性酒精性中毒时可大于5%。

各种血细胞模式图1.红细胞2.嗜酸性粒细胞3.嗜碱性粒细胞4.中性粒细胞5.淋巴细胞6.单核细胞7.血小板红细胞聚集分布成熟红细胞随机呈块状或束状聚集在一起,临床主要表现为以下病症:1.多种抗体暴露;2.溶血性贫血(自身免疫性);3.非典型肺炎;4.金葡菌感染;5.冷凝集疾病。
靶形红细胞红细胞中央色深,外周以苍白圈,在近红细胞边缘处又较深。
形同射击之靶,在正常情况下靶形细胞极少见。
但在黄疸、肝病、脾切除后,缺铁性贫血,尤其是在地中海贫血的血涂片上颇为常见。
镰状红细胞这种红细胞两端尖锐,长而狭,形如镰刀样,见于先天性镰状红细胞贫血和Hb-C病等Bite Cell 红细胞由于细胞血红蛋白变性或沉淀成块,使细胞呈半圆形,提示可能有红细胞膜的缺乏,如G-6-PD缺乏症。
水滴形红细胞红细胞形态如梨形或水滴形,见于各种增生性贫血及骨髓纤维化,以及地中海贫血、脾功能亢进或肾病等。
固缩红细胞红细胞中有一侧清晰区,而血红蛋白浓缩偏向另一侧,临床上常见于婴儿固缩红细胞增多症。
半月形红细胞胞体巨大,呈月形,淡红色。
为衰老红细胞在制片时人工造成,或见于某些增生性贫血、血小管球性肾炎。
刺毛红细胞亦称锯凿细胞。
包括刺细胞、钻细胞及距细胞。
往往见于微血管病性溶血性贫血、丙酮酸激酶缺乏症、PNH,距细胞多见于肝脏疾病,钻细胞也见于尿毒症。
球形红细胞此种红细胞直径缩短,厚度增加,细胞中心区的血红蛋白比周围多,呈小球形状。
常见于遗传形红细胞增多症、自身免疫性溶血性贫血、异常血红蛋白病(如Hb-S等)。
椭圆形红细胞红细胞呈椭圆形,横径缩短,长径增大,正常人椭圆形红细胞也可高达15%。
这种红细胞多见于遗传性椭圆形红细胞增多症,这种红细胞至少占25%,一般要高于25%-50%才有诊断价值。
在大红细胞性贫血可达25%,恶性贫血及严重缺铁性贫血、地中海贫血及镰刀形贫血也可见此细胞。
口形红细胞口形红细胞的中心淡染区呈条状,这种细胞正常小于4%,增高见于口细胞增多症,急性酒精性中毒时可大于5%。

彩图A1彩图A2彩图A3彩图A4彩图A5彩图A6彩图A7彩图A8彩图A9彩图A10彩图A11彩图A12彩图A13彩图A14彩图A15彩图A16彩图A17彩图A18彩图A19彩图A20彩图A21彩图A22彩图A23彩图A24彩图A25彩图A26彩图A27彩图A28彩图A29彩图A30彩图A31彩图A32彩图A33彩图A34彩图A35彩图A36彩图A37彩图A38彩图A39彩图A40彩图A41彩图A42彩图A43彩图A44彩图A45彩图A46彩图A47彩图A48彩图A49彩图A50彩图A51彩图A52彩图A53彩图A54彩图A55彩图A56彩图A57彩图A58彩图A59彩图A60彩图A61彩图A62彩图A63彩图A64彩图A65彩图A66彩图A67彩图A68彩图A69彩图A70彩图A71彩图A72彩图A73彩图A74彩图A75彩图A76彩图A77彩图A78彩图A79彩图A80彩图A81彩图A82彩图A83彩图A84彩图A85彩图A86彩图A87彩图A88彩图A89彩图A90彩图A91彩图A92彩图A93彩图A94彩图B1彩图B2彩图B3彩图B4彩图B5彩图B6彩图B7。

血液组织学及切片
彩色图谱
1.红细胞:双凹圆盘状,成熟红细胞无核无细胞器,质内充满血红蛋白使其呈红色
2.中性粒细胞:数量最多的白细胞,核深染呈弯曲杆状或分叶状(2-5叶)。
核呈浅粉红色,含许多浅紫色或浅红色颗粒
3.碱粒:数量最少,核分叶或S型或不规则形,着色浅,胞质含蓝紫色嗜碱性颗粒,大小不等,可将核掩盖
4.酸粒:核多为2叶,胞质充满粗大的鲜红色嗜酸性颗粒
5.单核细胞:体积最大的白细胞,核呈肾型、马蹄铁型或扭曲不规则型,染色质颗粒细且松散,着色浅。
胞质丰富,因若嗜碱性而呈
灰蓝色。
在血液中停留12-48小时后进入结缔组织或其他组织,分化为巨噬细胞
6.淋巴细胞:小淋巴细胞核圆,一侧常有浅凹,染色质浓呈块状,着色深。
中淋巴细胞核染色质略稀疏,着色浅,有的可见核仁,胞
质少,仅在核周很薄的一圈。
淋巴细胞胞质为嗜碱性,呈蔚蓝色,胞质较多,含嗜天青颗粒。
7.血小板,是从骨髓巨核细胞脱落下来的胞质小块,非严格意义上的细胞。
呈双吐圆盘状,中央有蓝紫色血小板颗粒,周边呈均质浅
蓝色,称透明区。
天马波波
天马波波。